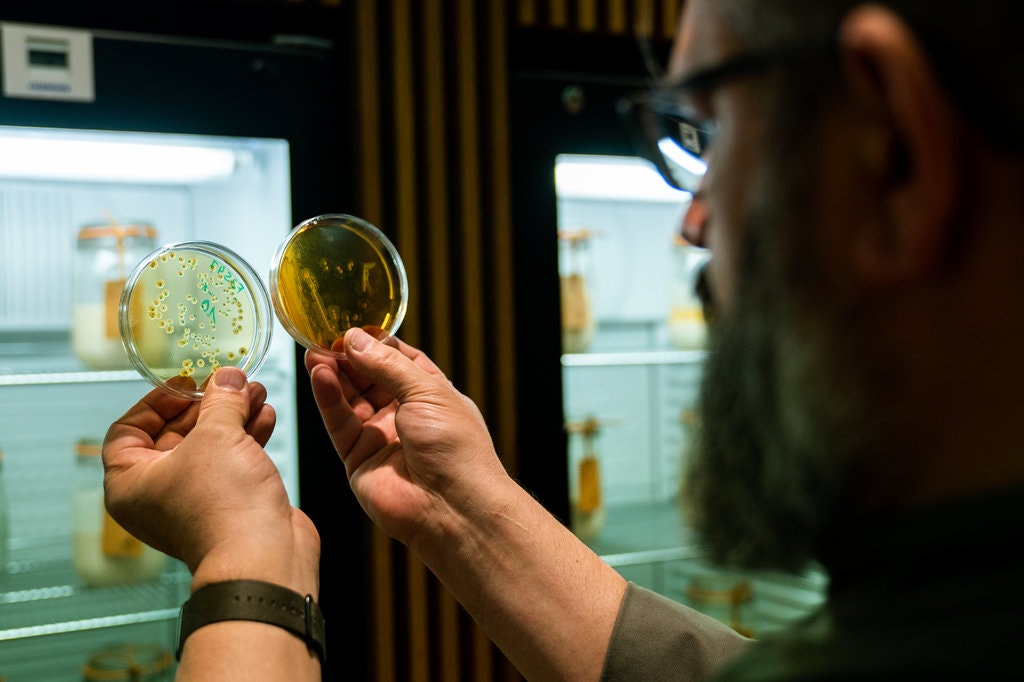
00SCI-SOURDOUGH2-jumbo

Jadon Smith is one of six teen curators for “Black Histories, Black Futures,” the first exhibition at the Museum of Fine Arts, Boston, curated entirely by high school students. photo credit: Melanie Stetson Freeman/Staff
Although the exhibit highlighted here began in January (notably directly following the holiday honoring MLK), we have the CS Monitor to thank for bringing it to our attention. The museum is currently closed due to the coronavirus outbreaks, but the making of video on the MFA website shows some highlights, and we can only hope that there will be opportunity to visit it in person before the end date of June 20th.
“The teen curators—fellows from youth empowerment organizations Becoming a Man (BAM), The BASE, and the Bloomberg Arts Internship Boston program managed by EdVestors—used skills they developed as paid interns in a pilot internship program at the MFA to research, interpret, and design the exhibition. Their work highlights areas of excellence within the Museum’s collection and lays foundations for the future.”
Jadon Smith steps closer to his favorite painting by Archibald Motley, carefully examining the details he’s looked at many times before, a smile from ear to ear. At the center of the piece, five elegant women dressed in their Sunday best sit in a restaurant. One woman, hidden in the background, catches his attention.

The John Axelrod Collection/Frank B. Bemis Fund, Charles H. Bayley Fund, and the Heritage Fund for a Diverse Collection/Courtesy of The MFA “Cocktails” by Archibald Motley is an oil on canvas painting from about 1926. Motley was known for depicting the blossoming of black social life.
“Women are the centerpiece of the whole entire painting,” says Jadon, a junior at John D. O’Bryant School of Mathematics and Science, during a visit to Boston’s Museum of Fine Arts in early March. “They’re supposed to be there to be seen. Don’t ignore them. Notice that they’re there, appreciate the fact that they’re there.”
Jadon is one of six local teens selected to craft “Black Histories, Black Futures” – the museum’s first exhibition curated entirely by high school students. The MFA’s exhibition, the culmination of a partnership with local youth empowerment organizations, reflects a growing trend, one that has museums working to engage and represent a more diverse population within the field of fine art. Including young people in the curation process not only trains the next generation of curators, say museum staffers, but it also helps aging institutions display refreshing and inclusive exhibitions inspired by the young curators’ own experiences.
“This institution is 150 years old. And so what does that mean for young people? Where do young people belong in such an old institution?” says Layla Bermeo, an associate curator at the MFA. “This project really tried to argue that young people belong in the center.”.. Continue reading →







 As we
As we 
 This morning we will dig holes for the first of the shade trees going onto that land where the coffee will be planted. But first, the news. The best I could find, for motivation, involves a man temporarily in New York City, working in a museum. His work, and the exhibition he is tending to, provides me context for the countryside as it still is for many coffee farmers here, and the technology transforming the countryside for future generations. Already plenty of coffee farmers are using technology as advanced as that of the tomato man in the story below. Without romanticizing the hard labor of traditional coffee farming, the work we are doing makes me more appreciative of the coffee farmers we source from. Thanks to Elizabeth A. Harris for this story:
This morning we will dig holes for the first of the shade trees going onto that land where the coffee will be planted. But first, the news. The best I could find, for motivation, involves a man temporarily in New York City, working in a museum. His work, and the exhibition he is tending to, provides me context for the countryside as it still is for many coffee farmers here, and the technology transforming the countryside for future generations. Already plenty of coffee farmers are using technology as advanced as that of the tomato man in the story below. Without romanticizing the hard labor of traditional coffee farming, the work we are doing makes me more appreciative of the coffee farmers we source from. Thanks to Elizabeth A. Harris for this story:




 During those months–the shops fully opened in late November and until early March were nonstop full of guests–I had hundreds of conversations with travelers.
During those months–the shops fully opened in late November and until early March were nonstop full of guests–I had hundreds of conversations with travelers.